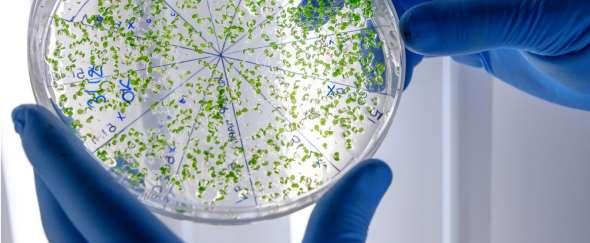

21 minute read
Cambios en la microbiota ocular y su relación con la superficie ocular: revisión del tema
Changes in the ocular microbiota and its relationship with the ocular surface: a review of the topic
Advertisement
REVISIÓN
DAYANNA SÁNCHEZ MAYORGA16 , SANDRA CAROLINA DURÁN CRISTIANO17
Citación: Sánchez Mayorga D, Durán Cristiano SC. Cambios en la microbiota ocular y su relación con la superficie ocular: revisión del tema. Revista Kontactology. 2020; 2(1): 49-57.
RESUMEN
La microbiota ocular (MO) hace referencia a un conjunto de microorganismos con la capacidad de modular la respuesta inmunológica de la superficie ocular, y mantener la homeostasis y protección ocular, cuyos cambios asociados al uso indiscriminado de antibióticos, pueden generar desregulación de la expresión y actividad de sus microorganismos constitutivos y ocasionar señales conducentes a daños anatómicos y funcionales de estructuras de la superficie ocular como la película lagrimal, párpados, conjuntiva y córnea. La revisión del tema describe las generalidades de la microbiota ocular y su papel en la superficie ocular, así como su relación con el uso de lentes de contacto. Se sugiere que la disbiosis ocular se asocia con numerosas alteraciones del segmento anterior ocular como ojo seco, blefaritis y disfunción de glándulas de Meibomio. Finalmente destaca las medidas de prevención para evitar su desregulación y trastornos asociados de la superficie ocular, además de perspectivas para futuras investigaciones del tema desde la ciencia básica y clínica. Se concluye que la microbiota ocular influye en eventos biológicos y homeostáticos importantes que deben considerarse, en tanto que muchas patologías asociadas o no al uso de lentes de contacto tienen un impacto en la actividad de la microbiota ocular. Palabras clave: Lentes de contacto, Superficie ocular, microbiota ocular, conjuntiva, lágrima.
ABSTRACT
The ocular microbiota (OM) refers to a set of microorganisms that have the ability to modulate the immune response of the ocular surface and maintain homeostasis and protection of the eye. Changes in OM, associated with the indiscriminate use of antibiotics, can generate a dysregulation in the expression and activity of the microorganisms that make it up and cause signals that lead to anatomical and functional damage to the structures that make up the tear surface, including: the film lacrimal, eyelids, conjunctiva, cornea etc. Therefore, this review will describe the generalities of the ocular microbiota and its role on the ocular surface, and the relationship between the microbiota and the use of contact lenses will be defined. From the reviewed literature, it is suggested that ocular dysbiosis has been associated with a large number of alterations in the anterior segment of the eye, such as dry eye, blepharitis,
16Estudiante X Semestre de Optometría. Universidad de la Salle, Bogotá Colombia. 17 Optómetra, Msc Biomédicas. Docente Universidad de la Salle. Autor responsable de la correspondencia: sduran@unisalle.edu.co, dayannasanchez16@unisalle.edu.co.
and meibomian gland dysfunction. Finally, prevention measures are highlighted to avoid its dysregulation and therefore associated ocular surface disorders, as well as perspectives for future research on the subject from the area of basic and clinical science. As a conclusion, it is evident that the ocular microbiota influences important biological events that maintain ocular homeostasis that must be taken into account, since many of the pathologies associated or not with the use of contact lenses have an impact on the activity of the microbiota. ocular. Keywords: Ocular microbiota, ocular Surface, contact lenses, conjunctiva, tear film.
INTRODUCCIÓN
La microbiota o microbioma es un conjunto de microorganismos que residen y colonizan varias partes del cuerpo, y poseen funciones esenciales de defensa patogénica en cuanto contribuyen al desarrollo de la respuesta inmunológica corporal [1]. El sistema inmunológico tiene un papel fundamental en la conformación de la microbiota, pues el primero enfrenta continuamente una gran carga microbiana y evita patologías derivadas de la señalización inmune innata, o alteraciones de la microbiota que afectan sus funciones metabólicas mediante la estratificación y compartimentación, mecanismos que minimizan el contacto directo de las bacterias con la superficie de las células epiteliales, y confinan a estas limitando su capacidad penetrante [2,3]. El ojo cuenta con su propia microbiota especialmente en la conjuntiva y la lágrima, donde se encuentran la lisozima (enzima) y otras moléculas que limitan el crecimiento bacteriano. En tal sentido, la presente revisión describe los aspectos relevantes de la microbiota ocular, su afectación secundaria a la prescripción de algunos medicamentos, o el uso inadecuado de lentes de contacto, que perturban la homeostasis del sistema, tan esencial para la etiología, manejo y prevención de patologías en la superficie ocular, por parte del profesional de la salud visual.
Generalidades de la microbiota Los humanos coexistimos con microorganismos que habitan zonas corporales como la boca, piel, tracto gastrointestinal, sistema genitourinario y mucosas corporales. La microbiota y el ser humano interaccionan entre sí, autorregulando su concentración numérica y dinámica metabólica, estableciendo influyendo a la vez en el estado de salud o enfermedad [4,6]. Actualmente se conocen según el proyecto Microbioma Humano, más de 100 billones de microorganismos simbióticos que residen en el ser humano y modulan respuestas biológicas esenciales, como la proliferación y señalización celular, la respuesta inmune y actividad neuronal, entre otras [1]. La microbiota -entendida como sofisticada agrupación viral, bacteriana, micótica, parasitaria y de arqueas- juega un papel inmunológico fundamental, en tanto que la relación entre estos los sistemas microbiota - inmunológico, favorece una respuesta protectora y efectiva contra los patógenos [4,6]. La microbiota puede regular procesos de salud y enfermedad, de modo que su imbalance puede conducir a eventos no deseados en la salud [7], como se evidencia en publicaciones recientes que abordan la desregulación de la microbiota como modulador de respuestas de estrés celular, activación de mediadores inflamatorios y déficit de actividad neuroprotectora [8-10]. Desde hace décadas, estudios experimentales han descrito la existencia de microorganismos simbióticos que contribuyen en el desarrollo normal del ser humano, e incluso algunos análisis sugieren que regulan la respuesta inmunológica, el metabolismo de algunos nutrientes, la arquitectura intestinal y en los últimos años, se ha revelado su rol en la neuro modulación [7]. Fan-Y et al., sugieren al respecto, que las bacterias simbióticas presentes en la microbiota intestinal, modulan la respuesta de tolerancia inmunológica, e inhiben algunos factores de transcripción que se asocian a la expresión de un fenotipo Th17 [11,12]. Por otro lado, factores epigenéticos asociados a la actividad física, dieta, nutrición, consumo de medicamentos, cambios hormonales, y edad entre otros, pueden generar un fuerte impacto en la microbiota [13,14]. En efecto, Vila et al., sugieren cambios en el número y tipo de microorganismos constituyentes de la microbiota, después del uso de metformina,
lo que demuestra que el uso de algunos fármacos podría tener un impacto importante en la composición de la microbiota, como lo confirman otras investigaciones [15–17]. Pese, a que en la literatura existe suficiente evidencia científica que respalda el papel de la microbiota en los sistemas anteriormente descritos como el nervioso y gastrointestinal, es plausible que según las propiedades biológicas de la mucosa intestinal y ocular, puedan tener un rol importante en la superficie ocular.
Microbiota ocular La superficie ocular está compuesta por un estrato celular epitelial, que en forma común conforma la glándula lagrimal, conjuntiva, párpados y córnea como sistemas glandular principal y accesorio que, trabajando integralmente, mantienen la homeostasis del segmento anterior ocular [18], lo que por consiguiente obliga a los mediadores moleculares y celulares a estar en comunicación permanente para preservar la salud ocular; en tal sentido, los mediadores del sistema inmunológico juegan un rol relevante en esta regulación, toda vez que un número importante de medidores del sistema
Tabla 11. Microorganismos presentes en la superficie ocular.
Bacterias gram positivas (+)
Staphylococcus coagulasa negativos (s. epidermidis) Propinobacterium sp. Diftiroides (corynebacterium sp.) Micrococcus sp. S. aureus Streptococcus sp. Eubacterium sp. Clostridium sp.
La aplicación de la biología molecular en el estudio de la patología ocular, ha permitido ampliar la información sobre la composición de la comunidad bacteriana presente en la superficie ocular, mediante estudios como el de Willcox et al., quienes describen mediante el análisis PCR reacción cadena de polimerasa- del gen del ARNr 16s obtenido del ácido desoxirribonucleico (ADN) de una muestra de conjuntiva sana, los microorganismos que residen en este tejido [22]. Por su parte, Ozkcan et al. realizan una amplificación y secuenciación del gen ARNr 16s de una muestra de conjuntiva limbal y fondo de saco, variadas comunidades bacterianas del género Pseudomonas spp, distinto al reportado para el microbioma de la superficie ocular [23].
innato y adaptativo circulan en la córnea, conjuntiva y película lagrimal, olvidando en ocasiones el rol de la microbiota en la homeostasis ocular, como una función requerida para evitar procesos patológicos. Algunos autores como Wang et al., demuestran han demostrado al respecto la participación de la microbiota ocular en dicho proceso, por lo que al alterarla podría facilitarse el desarrollo de la patología ocular [7,19]. El término microbiota ocular, hace referencia a los microorganismos comensales y patógenos que colonizan el ojo [20] a nivel conjuntival, palpebral y lagrimal, cuya composición puede afectarse en razón a su proximidad con la conjuntiva, el flujo lagrimal y sus componentes antibacterianos. La microbiota conjuntival de sujetos sanos, se compone en su mayoría por estafilococos coagulasa negativos, que son bacterias aisladas encontradas a nivel de lágrima, párpados y conjuntiva ocupando aproximadamente el 50% del frotis conjuntival y lagrimal, y hasta más del 50% en frotis palpebrales, además de otros microorganismos en menor proporción, según se exponen en la siguiente tabla [21].
Bacterias gram negativas (-)
Moraxella sp. (branhamella catarrhalis) Pseudomonas sp. Neisseria sp. Proteus sp.

Figura 9. Representación de las bacterias a nivel filo, presentes en la microbiota ocular y representación de las bacterias a nivel de género en el sistema operativo (21).
Microbiota y uso de antibióticos oftálmicos Aunque el uso de antibióticos es esencial en el manejo de procesos infecciosos y la preservación de millones de vidas, su uso indiscriminado, automedicación y uso crónico han generado cambios en la microbiota humana, alterado la selección de patógenos oportunistas y microbios mutualistas del cuerpo humano, que interactúan para ejecutar numerosos procesos fisiológicos como la regulación homeostática, metabólica e inmunológica, lo que conlleva a una perturbación de tal equilibrio y la generación de enfermedades agudas y crónicas [24,25]. En ese sentido, la Organización Mundial de la Salud (OMS) y la Organización Panamericana de Salud (OPS) han alertado sobre la resistencia bacteriana, como una problemática pública [26] de altísima relevancia clínica en la salud visual y ocular.

Figura 10. Efectos de los antibióticos en la microbiota humana. Fuente: elaboración propia.
Respecto a la salud visual, algunos estudios sugieren que el uso excesivo y descontrolado de antibióticos no solo puede modular la resistencia bacteriana hacia la antibioticoterapia, sino que puede inducir cambios de la flora bacteriana normal de la conjuntiva y párpados, afectando además la homeostasis de la superficie lagrimal [25,27]. El uso de medicamentos tópicos oculares -según lo descrito por Ozkan et al-, produce cambios en la superficie ocular que resultan proporcionales al tiempo y regularidad de uso de dichos medicamentos, en cuanto los investigadores reportan enrojecimiento moderado o leve de la conjuntiva bulbar ocular y
reducción de microbiota conjuntival y palpebral, como hallazgos asociados al uso inadecuado de antibióticos como la ciprofloxacina [27], que debe prescribirse bajo condiciones estrictamente necesarias. En los últimos años, la resistencia microbiana a los antibióticos ha sido un tema de interés en salud pública, debido a sus elevados porcentajes que agotan los recursos profesionales para combatir las infecciones. Microorganismos gram negativos y gram positivos develaron elevadas tasas de resistencia a medicamentos como la gentamicina, tobramicina y ciprofloxacina en 64,4%, 40.3% y 29.1% respectivamente, como resultados que concuerdan con el estudio de Hernández et al., quienes demostraron que las bacterias gram positivas ofrecían mayor resistencia al trimetoprim sulfamethozaxole (SXT); así como los gram negativos al trimetropin sulfamethozaxole y la tobramicina [28,30]. Según lo anterior, se evidencia una alta tasa de resistencia presuntamente asociada por la interacción entre el uso de antibióticos y la desregulación de la microbiota ocular [19,25]. Según las razones expuestas, el uso de antibióticos requiere una administración responsable en lo que respecta a su adecuada dosificación, para mantener la microbiota del segmento anterior ocular y la homeostasis en el microambiente ocular.
Microbiota y superficie ocular La comprensión etiopatológica y el manejo oportuno de las infecciones bacterianas conjuntivales y corneales, son factores determinantes para prevenir cambios de la superficie ocular, y evitar patologías palpebrales que puedan conllevar a disfunción de glándulas de meibomio (DGM), como principal causa conocida del ojo seco evaporativo, una condición común que sumada a largas jornadas de exposición a dispositivos tecnológicos y otras predisposiciones, pueden empeorar la situación ocular del paciente. En tal sentido, el análisis de las muestras y la identificación del patógeno específico asociado con la infección ocular, permiten prescribir el antibiótico más acertado sin propiciar la resistencia bacteriana, además de evitar cambios fisiológicos beneficiosos de la microbiota ocular [31,32]; se sabe que las bacterias son los principales agentes patogénicos palpebrales, y que la flora bacteriana puede causar disfuncionalidad de las glándulas de Meibomio [33]; también se ha asociado la queratoconjuntivitis meibomiana con la blefaritis anterior, como condición mayormente afectante de glándulas de Meibomio, que se manifiesta como inflamación de la superficie ocular y responsable frecuente de síntomas de blefaritis crónica [31]. La disfuncionalidad de las glándulas de Meibomio constituye la principal causa de ojo seco evaporativo, y según los estudios, las bacterias adheridas a los márgenes palpebrales forman biopelículas que actúan como refugio, favorecen la multiplicación microbiana y aumentan la densidad de colonias -algunas pertenecientes a la microbiota ocular- responsables de la producción de mediadores proinflamatorios como citoquinas y proteasas [32].
Microbiota ocular y lentes de contacto Los lentes de contacto son dispositivos médicos empleados en la corrección óptica y apoyo terapéutico, siendo esta última utilidad aplicada en casos de conjuntivitis y queratitis, que hacen necesario seleccionar su uso personalizado de acuerdo con la necesidad del paciente. Es sabido que la adaptación de lentes de contacto blandos, rígidos o esclerales- requiere una integralidad de la superficie ocular, y la prevención de patologías de los anexos oculares que eventualmente desencadenen disfunción de las glándulas de Meibomio y ojo seco evaporativo [31,32].
Los usuarios de lentes de contacto presentan mayor riesgo de contraer patógenos potenciales, principalmente bacterias gram negativas y colonias del tipo Corynebacterium y Propinebacterium, además de presentar en su microbioma conjuntival más de tres veces el número habitual de Methylobacterium, Lactobacillus, Acinetobacter y Pseudomonas, lo que sugiere un vínculo entre los microorganismos cutáneos y los responsables de las infecciones
oculares [19, 34]. Por consiguiente, el uso inadecuado de lentes de contacto contribuye a la desregulación de la microbiota ocular, y al consecuente desarrollo de alteraciones en la superficie ocular [34]. Por otro lado, la relación entre el uso de lentes de contacto y la microbiota de la superficie ocular puede asociarse con la adherencia de colonias bacterianas que conformar esta última, constituidas por los géneros Enterococcus, Streptococcus, Halomonas, Corynebacterium, Staphylococcus y Acinetobacter [35].
Por otra parte, los lentes de contacto pueden favorecer la formación de una biopelícula (biofilm) cuando este dispositivo médico no recibe maniobras adecuadas de limpieza, o el usuario destaiende las instrucciones de uso antes de insertar el lente en el ojo, con lo cual aumenta la posibilidad de contraer una infección grave como ocurre con la Serratia Marcescens, que suele presentarse en las biopelículas de lentes de hidrogel. Según el tipo de lentes, los hidrofílicos blandos presentan menor cantidad de Bacillus, Lactobacillus y Tatumella, mientras que los lentes orto-k poseen en mayor número las bacterias antes descritas, adicionando la E. meningoseptica y D. acidovorans [36, 37]. Considerando las investigaciones sobre microbiota y lentes de contacto, se precisa sobre la importancia del uso adecuado de los lentes y sus soluciones para preservar la salud de la superficie ocular, toda vez que la contaminación del lente se asocia con la colonización de numerosos microorganismos patógenos como H. Influenzae, que, según Zhang et al., es uno de los mayores responsables de la conjuntivitis bacteriana, particularmente en lactantes [19]. Willcox et al. identificaron la presencia de Pseudomonas spp. -específicamente P. Aeruginosa y S. Marcescens- en lentes de contacto, como causantes de síntomas de ojo rojo agudo y queratitis secundarios al sobre uso [36], lo que pone en evidencia que el usuario de lentes de contacto debe seguir las indicaciones del profesional de la salud, para evitar cambios desfavorables en la microbiota ocular y el desarrollo de enfermedades oculares que posteriormente pueden imposibilitar el uso de estos dispositivos médicos. Otro factor influyente en las variaciones en la microbiota ocular es el material de los lentes de contacto, pues algunos estudios asocian el HEMA con el incremento de colonias de estafilococos coagulasa negativo, especialmente en párpados y conjuntiva, haciendo del uso de lentes de contacto un factor de riesgo para causar queratitis, conjuntivitis microbiana y otras infecciones oculares [38, 39]. En tal sentido se destacan numerosas investigaciones en curso sobre los diferentes materiales de lentes de contacto blandos desde la perspectiva microbiológica, especialmente en aquellos mayormente utilizados a nivel mundial.
Futuras perspectivas A partir de la discusión general y los subtemas alusivos al microbioma ocular, las investigaciones recientes y futuras pueden enfocarse en diferentes perspectivas según su relevancia clínica, para brindar mayor beneficio e impacto social mediante las siguientes actividades:
- Ampliar la información sobre la microbiota ocular y fomentar investigaciones que caractericen sus funciones y composición, desde el enfoque de la terapéutica farmacológica y los hábitos saludables para el profesional de la salud visual y ocular. - Estudiar las alteraciones de la superficie ocular derivadas de cambios en la microbioma ocular, considerando que esta unidad anatomofuncional es esencial para la salud visual y ocular, especialmente en pacientes usuarios de lentes de contacto, y para quienes desde la consulta debe promoverse un manejo e higiene más adecuadas para su uso saludable y eficiente. - Comprender mediante la biología molecular aplicada a la salud ocular, los eventos biológicos asociados con patologías oculares, toda vez que futuras investigaciones podrían aplicar estas metodologías para entender las patologías de superficie ocular, y su asociación con el imbalance de la microbiota ocular, tanto
en usuarios como no usuarios de lentes de contacto.
CONCLUSIONES
La microbiota ocular está directamente relacionada con la función homeostática protectora y reguladora de la superficie ocular, toda vez que las variaciones en el número de microorganismos y la colonización transitoria de flora en la superficie ocular, pueden originar patologías conjuntivales, palpebrales y corneales como la disfunción de glándulas de Meibomio, una condición asociada con cambios en la microbiota que produce ojo seco evaporativo, con consecuente dificultad para adaptar de lentes de contacto dados los síntomas oculares agregados, lo que hace que el microbioma ocular se haya convertido en un tema de interés clínico, particularmente durante la última década. La higiene inadecuada de los lentes de contacto es un factor que favorece la formación de biopelículas con altas cargas de patogenicidad, capaces de generar cambios en la superficie ocular, y tanto en la composición como la actividad de la microbiota ocular. El material de los lentes de contacto es un factor condicionante para el aumento de bacterias en su superficie, y una consecuente desregulación de la microbiota ocular, por lo que resulta una variable a considerar cuando existen sospechas o alteraciones confirmadas de la unidad funcional lagrimal (UFL).
CONFLICTO DE INTERESES
Los autores del presente artículo declaran bajo la gravedad de juramento, que no existe ningún conflicto de interés académico, con laboratorios ni patrocinadores que eventualmente tengan participación o afectación en la gestión de publicación de este material. De igual forma, manifiestan que no existen fuentes de financiación de terceros que comprometan su voluntad libre y espontánea para someter este documento a arbitraje científico y publicación por parte de Revista Kontactology.
REFERENCIAS
1. Altveş S, Yildiz HK, Vural HC. Interaction of the microbiota with the human body in health and diseases. Biosci microbiota, food Heal. 2020;39(2):23–32. 2. Icaza Chávez ME.
Microbiota intestinal en la salud y la enfermedad. Rev.Gastroenterol. México. 2013; 78(4):240-8. 2. La Rosa Hernández D, Gómez Cabeza EJ, Sánchez Castañeda N. La microbiota intestinal en el desarrollo del sistema inmune del recién nacido. Rev.Cubana.Pediatr. 2014; 86(4):502-13. 3. Belkaid Y, Harrison OJ. Homeostatic immunity and the microbiota. Immunity. 2017; 46(4):56276. 4. Perozo Mena A. Microbioma Humano. Editorial Kasmera. 2018; 46(2):95-8. 5. Alarcón P, González M, Castro É. Rol de la microbiota gastrointestinal en la regulación de la respuesta inmune. Rev.Med.Chil. 2016; 144(7):910-6. 6. Wang B, Yao M, Lv L, Ling Z, Li L. The human microbiota in health and disease. Engineering. 2017; 3(1):71-82. 7. Minter MR, Hinterleitner R, Meisel M, Zhang C, Leone V, Zhang X, et al. Antibiotic-induced perturbations in microbial diversity during post-natal development alters amyloid pathology in an aged APP(SWE)/PS1(ΔE9) murine model of Alzheimer’s disease. Sci.Rep. 2017; 7(1):10411. 8. Sampson TR, Debelius JW, Thron T, Janssen S, Shastri GG, Ilhan ZE, et al. Gut microbiota regulate motor deficits and neuroinflammation in a model of Parkinson’s Disease. Cell. 2016; 167(6):1469-80.e12.
9. Marizzoni M, Provasi S, Cattaneo A, Frisoni GB. Microbiota and neurodegenerative diseases.
Curr.Opin.Neurol. 2017; 30(6):630-8. 10. Fan Y, Pedersen O. Gut microbiota in human metabolic health and disease. Nat.Rev.Microbiol. [Internet]. 2021; 19(1):55-71. 11. Sekirov I, Russell SL, Antunes LCM, Finlay BB. Gut microbiota in health and disease. Physiol.Rev. [Internet]. 2010; 90(3):859-904. 12. Qin Y, Wade PA. Crosstalk between the microbiome and epigenome: messages from bugs.
J.Biochem. 2018; 163(2):105-12. 13. Sharma M, Li Y, Stoll ML, Tollefsbol TO. The epigenetic cnnection between the gut microbiome in obesity and diabetes. Front.Genet. 2020; 10:1329. 14. Vich Vila A, Collij V, Sanna S, Sinha T, Imhann F, Bourgonje AR, et al. Impact of commonly used drugs on the composition and metabolic function of the gut microbiota. Nat.Commun. 2020; 11(1):362. 15. Walsh J, Griffin BT, Clarke G, Hyland NP. Drug-gut microbiota interactions: implications for neuropharmacology. Br.J.Pharmacol. 2018; 175(24):4415-29. 16. Wu H, Esteve E, Tremaroli V, Khan MT, Caesar R, Mannerås-Holm L, et al. Metformin alters the gut microbiome of individuals with treatment-naive type 2 diabetes, contributing to the therapeutic effects of the drug. Nat.Med. 2017; 23(7):850-8. 17. Gipson IK. The ocular surface: the challenge to enable and protect vision: the Friedenwald lecture. Invest.Ophthalmol.Vis.Sci. 2007 Oct; 48(10):4390-8. 18. 19. Zhang H, Zhao F, Hutchinson DS, Sun W, Ajami NJ, Lai S, et al. Conjunctival microbiome changes associated with soft contact lens and orthokeratology lens wearing.
Invest.Ophthalmol.Vis.Sci. 2017; 58(1):128-36. 19. Wen X, Hu X, Miao L, Ge X, Deng Y, Bible PW, et al. Epigenetics, microbiota, and intraocular inflammation: New paradigms of immune regulation in the eye. Prog.Retin.Eye.Res. 2018; 64:84-95. 20. Dong Q, Brulc JM, Iovieno A, Bates B, Garoutte A, Miller D, et al. Diversity of bacteria at healthy human conjunctiva. Investig.Ophthalmol.Vis.Sci. 2011; 52(8):5408-13. 21. Willcox MDP. Characterization of the normal microbiota of the ocular surface. Exp.Eye.Res. 2013; 117:99-105. 22. Ozkan J, Coroneo M, Willcox M, Wemheuer B, Thomas T. Identification and visualization of a distinct microbiome in ocular surface conjunctival tissue. Invest.Ophthalmol.Vis.Sci. 2018; 59(10):4268-76. 23. Francino MP. Antibiotics and the human gut microbiome: Dysbioses and accumulation of resistances. Front.Microbiol. 2016; 6:1-11. 24. Langdon A, Crook N, Dantas G. The effects of antibiotics on the microbiome throughout development and alternative approaches for therapeutic modulation. Genome.Med. 2016; 8(1). 25. Organization WH. Resistencia a los antimicrobianos [Internet]. Available from: https://www3.paho.org/hq/index.php?option=com_content&view=article&id=11129:amrantimicrobial-resistance-intro&Itemid=41534&lang=es#:~:text=La resistencia a los antimicrobianos se produce cuando los microorganismos,o antihelmínticos%2C por ejemplo). 26. Ozkan J, Zhu H, Gabriel M, Holden BA, Willcox MDP. Effect of prophylactic antibiotic drops on ocular microbiota and physiology during silicone hydrogel lens wear. Optom.Vis.Sci. 2012; 89(3). 27. Hernández Rodríguez P, Mesa DL, Quintero G. Aislamiento y susceptibilidad de especies bacterianas sin reporte previo como causantes de infección ocular en segmento anterior.
Cienc.Tec.Salud.Vis.Ocul. 2006; 0(6):61-9.
28. Galvis V, Parra MM, Tello A, Castellanos YA, Camacho PA, Villarreal D, et al. Perfil de resistencia antibiótica en infecciones oculares en un centro de referencia en Floridablanca, Colombia.
Arch.Soc.Esp.Oftalmol. 2019; 94(1):4-11. 29. Hernández-Camarena JC, Bautista-de Lucio VM, Chirinos-Saldaña P, Navas A, Ramírez-Miranda
A, Climent-Flores A, et al. Queratitis infecciosas: Tendencias microbiológicas y sensibilidad a antibióticos. Segundo reporte anual del Grupo de Estudio de Microbiología Ocular del Instituto de Oftalmología “Conde de Valenciana.” Rev.Mex.Oftalmol. 2013; 87(2):100-9. 30. Cárdenas Díaz T, Hernández López I, Guerra Almaguer M, Cruz Izquierdo D, Miranda Hernández
I, Montero Díaz E. Rev.Cub.Oftalmol. Centro Nacional de Información de Ciencias Médicas; 2014; 90(1):264-71. 31. Alan G. Kabat, ODF. A new tool for managing ocular surface disease. Grupo Franja. (Dry eye):1. 32. Zhu M, Cheng C, Yi H, Lin L, Wu K. Quantitative analysis of the bacteria in blepharitis with demodex infestation. front microbiol. 2018; 9:1719. 33. Boost M, Cho P, Wang Z. Disturbing the balance: effect of contact lens use on the ocular proteome and microbiome. Clin.Exp.Optom. 2017; 100(5):459-72. 34. Retuerto MA, Szczotka Flynn L, Mukherjee PK, Debanne S, Iyengar SK, Richardson B, et al.
Diversity of ocular surface bacterial microbiome adherent to worn contact lenses and bacterial communities associated with care solution use. Eye.Contact.Lens. 2019; 45(5):331-9. 35. Willcox M, Sharma S, Naduvilath T, Sankaridurg P, Gopinathan U, Holden B. External Ocular surface and lens microbiota in contact lens wearers with corneal infiltrates during extended wear of hydrogel lenses. Eye.Contact.Lens. 2011; 37:90-5. 36. Linda R. Contact lens wear alter ocular microbiome. Health.Serv.J. 2002; 112(5836):12-5. 37. AA Al-Najjar M. An Overview of ocular microbiology: ocular microbiota, the effect of contact lenses and ocular disease. Arch.Pharm.Pharmacol.Res. 2019; 1(5). 38. Shin H, Price K, Albert L, Dodick J, Park L, Dominguez Belloa MG. Changes in the eye microbiota associated with contact lens wearing. MBio. 2016; 7(2):1-6.









